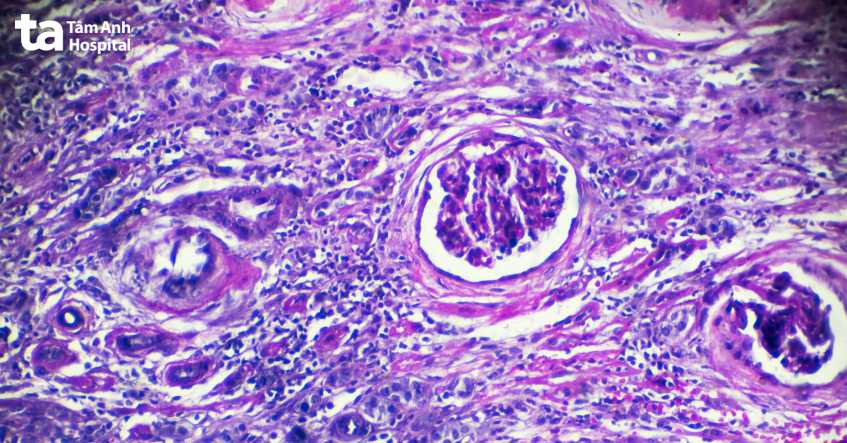
tế bào viêm cầu thận dưới kính hiển vi

Viêm cầu thận làm tổn thương bộ lọc ở cầu thận, ảnh hưởng xấu đến quá trình lọc máu và sức khỏe hệ bài tiết. Với những ảnh hưởng này, nhiều người lo lắng không biết liệu bệnh viêm cầu thận có nguy hiểm không? Có gây biến chứng gì không? Bài viết này sẽ giải đáp các thắc mắc của bạn về mức độ nguy hiểm và biến chứng của viêm cầu thận qua các chia sẻ của bác sĩ CKII Nguyễn Thị Huê, Trung tâm Tiết niệu – Thận học – Nam khoa, BVĐK Tâm Anh TP.HCM.

Bệnh viêm cầu thận rất nguy hiểm vì nếu không được chẩn đoán và điều trị kịp thời có thể dẫn đến tổn thương thận cấp tính (AKI) hoặc có thể tiến triển dần dần thành suy thận mạn tính. Suy thận ảnh hưởng nghiêm trọng đến chất lượng cuộc sống của người bệnh, thậm chí gây tử vong.
Viêm cầu thận chia thành 2 loại: viêm cầu thận cấp và viêm cầu thận mạn tính. Mỗi loại lại có nguyên nhân và đặc điểm lâm sàng khác nhau, cần định hướng nguyên nhân, đưa ra chẩn đoán và điều trị phù hợp, đem lại hiệu quả điều trị cho người bệnh. (1)
Viêm cầu thận là tình trạng viêm xảy ra ở cầu thận bao gồm viêm ở các tiểu cầu thận và các mạch máu trong thận. Nếu tổn thương tại cầu thận có thể có các biểu hiện như phù, tăng huyết áp, thay đổi thành phần nước tiểu, thiếu máu,… nếu không được can thiệp điều trị kịp thời, đúng cách, bệnh dễ gây các biến chứng nguy hiểm. Dưới đây là 8 biến chứng viêm cầu thận có thể gặp phải.
Suy thận cấp (AKI) là tình trạng chức năng thận suy giảm nhanh chóng, đột ngột, thường liên quan đến nguyên nhân nhiễm trùng gây viêm cầu thận. Nếu không được xử lý kịp thời, sự tích tụ chất thải và chất lỏng tăng cao có thể đe dọa tính mạng, phải xử trí bằng máy lọc nhân tạo (lọc máu). Nhưng bệnh này cũng có thể được chữa khỏi hoàn toàn. Những người có sức khỏe tốt có thể lấy lại được chức năng bình thường hoặc gần như bình thường của thận. (2)
Khi xuất hiện các triệu chứng suy thận cấp tính, người bệnh cần được điều trị ngay lập tức. Việc trì hoãn điều trị hoặc điều trị sai cách có thể khiến chức năng thận không phục hồi, dẫn đến suy thận mạn tính.
Suy thận mạn tính (CKD) là một tình trạng tiến triển trong đó thận dần mất khả năng hoạt động bình thường. Viêm cầu thận là một trong những nguyên nhân phổ biến của CKD. Viêm cầu thận mạn tính gây những tổn thương dây dẳng, kéo dài cho các đơn vị lọc máu. Khi các đơn vị này bị hỏng, chúng không thể lọc các chất thải từ máu hiệu quả.
Theo thời gian, điều này có thể dẫn đến suy thận mãn tính và cuối cùng là bệnh thận giai đoạn cuối, giai đoạn nặng nhất khiến thận mất hoàn toàn chức năng. Giai đoạn cuối cần phải điều trị thay thế thận như: Ghép thận, chạy thận nhân tạo hay thẩm phân phúc mạc (lọc màng bụng) giúp người bệnh duy trì sự sống.

Tăng huyết áp là một trong những biến chứng nguy hiểm của bệnh viêm cầu thận. Tổn thương cầu thận do viêm hoặc sẹo có thể dẫn đến tăng huyết áp. Viêm cầu thận và tăng huyết áp thường đi đôi với nhau. Điều này được lý giải do viêm cầu thận khiến thận bị suy giảm chức năng bởi các tổn thương đơn vị lọc mà viêm cầu thận gây ra. Khi thận không thể lọc máu một cách bình thường, dễ gây giữ nước và làm tăng lượng máu.
Trong hệ thống Renin-Angiotensin-Aldosterone (RAAS), thận đóng vai trò quan trọng trong việc điều hòa huyết áp. Chính vì vậy, khi viêm cầu thận gây tổn thương thận sẽ gây ra các bất thường trong hoạt động của hệ thống này, có thể khiến chúng hoạt động quá mức và làm huyết áp tăng cao. Bên cạnh đó, viêm cầu thận có thể lan sang các mạch máu ở thận, gây viêm mạch máu. Khi các mạch máu này viêm, chúng sẽ sưng lên và thu hẹp lại, dẫn đến tăng huyết áp.
Phù nề là là biến chứng nguy hiểm do viêm cầu thận cấp tính gây ra. Khi mức lọc cầu thận (GFR) giảm, các triệu chứng như phù nề và tăng huyết áp xảy ra, chủ yếu là do tình trạng giữ muối và nước, sau đó do kích hoạt hệ thống Renin-Angiotensin-Aldosterone (RAAS) và gây tăng huyết áp.
Bản thân viêm cầu thận không trực tiếp gây nhiễm trùng. Thay vào đó, tổn thương thận do viêm cầu thận có thể khiến người bệnh dễ bị nhiễm trùng hơn, vì:

Erythropoietin (EPO) là 1 hormon được thận sản xuất, đóng vai trò quan trọng trong quá trình tạo hồng cầu. Khi thận suy, sản xuất EPO giảm, gây giảm sản xuất hồng cầu, giảm nồng độ hemoglobin máu (thiếu máu). Hầu hết những người mắc bệnh thận sẽ bị thiếu máu. Thiếu máu có thể xảy ra sớm trong quá trình bệnh thận và trở nên trầm trọng hơn khi thận suy và không thể tạo ra EPO nữa. Điều này có thể xảy ra với các trường hợp viêm cầu thận gây bệnh thận (CKD).
Viêm cầu thận có thể dẫn đến suy tim theo nhiều cách khác nhau, như:
Đa phần các trường hợp biến chứng viêm cầu thận gây suy tim, thường do tích tụ chất lỏng, dẫn đến quá tải.
Viêm cầu thận có thể gây ra biến chứng là hội chứng thận hư hoặc hội chứng viêm thận. Khi hội chứng thận hư xuất hiện, người bệnh sẽ bị sưng tấy nhiều hơn và có nhiều protein trong nước tiểu. Khi hội chứng thận hư xuất hiện, người bệnh sẽ có máu trong nước tiểu và huyết áp cao kèm theo ít protein trong nước tiểu.
Điều này cũng dễ hiểu, vì các tiểu cầu khỏe mạnh giữ cho protein trong máu (chủ yếu là albumin) cần thiết để duy trì lượng chất lỏng thích hợp trong cơ thể, không thấm vào nước tiểu. Khi bị tổn thương, cầu thận sẽ thải quá nhiều protein trong máu ra khỏi cơ thể, dẫn đến hội chứng thận hư.
Thậm chí ngay cả khi được điều trị đúng cách, viêm cầu thận vẫn có thể âm thầm tiến triển các biến chứng. Cho nên, song song với việc điều trị, bác sĩ cần có phác đồ kiểm soát biến chứng và các tình trạng sức khỏe tiềm ẩn, có liên quan khác.

Nguyên nhân viêm cầu thận bao gồm:
Bệnh viêm cầu thận có thể chữa khỏi được không còn phụ thuộc vào lựa chọn điều trị khác nhau. Khả năng chữa khỏi bệnh phụ thuộc vào nguyên nhân gây bệnh, mức độ tổn thương cầu thận và thận, loại viêm cầu thận đang mắc phải. Trong một vài trường hợp hiếm gặp, viêm cầu thận có nguyên nhân do vi khuẩn, mức độ nhiễm trùng nhẹ thường có thể tự khỏi mà không cần điều trị.
Việc điều trị viêm cầu thận hiện nay nhắm mục tiêu vào việc bảo tồn chức năng thận và bảo vệ thận không bị tổn thương thêm. Mặc khác, viêm cầu thận thường có nguyên nhân liên quan đến các bệnh toàn thân, cho nên bác sĩ cần có kế hoạch điều trị giải quyết hoặc quản lý nguyên nhân. Các lựa chọn điều trị viêm cầu thận có sẵn bao gồm: liệu pháp miễn dịch (điều trị bằng thuốc uống hoặc truyền tĩnh mạch), lọc huyết tương, liệu pháp kết hợp,…

Chẩn đoán viêm cầu thận bằng phương pháp xét nghiệm đánh giá chức năng thận, bao gồm:

Viêm cầu thận cần gặp bác sĩ khi xuất hiện các dấu hiệu hoặc triệu chứng nghi ngờ mắc viêm cầu thận, chúng bao gồm:
Một số lưu ý dành cho người bệnh viêm cầu thận giúp người bệnh hiểu về tình trạng bệnh và duy trì sức khỏe tổng thể tốt hơn:
Như vậy, bệnh viêm cầu thận có nguy hiểm và có thể khiến người bệnh đối mặt với 8 biến chứng thường gặp như: suy thận cấp, suy thận mãn tính, tăng huyết áp, phù nề, nhiễm trùng, thiếu máu, suy tim và hội chứng thận hư. Việc điều trị kịp thời, đúng cách sẽ giúp kiểm soát các đợt viêm, giải quyết nguyên nhân và hạn chế nguy cơ mắc biến chứng.
Điều trị viêm cầu thận tại Trung tâm Tiết niệu – Thận học – Nam khoa, BVĐK Tâm Anh với đội ngũ bác sĩ là các chuyên gia giàu kinh nghiệm và tận tâm trong việc khám và điều trị các vấn đề về sức khỏe tiết niệu, thận và nam khoa, trong đó có viêm cầu thận.
HỆ THỐNG BỆNH VIỆN ĐA KHOA TÂM ANH
Hy vọng với các thông tin bài viết vừa chia sẻ đã giúp giải đáp thắc mắc về bệnh viêm cầu thận có nguy hiểm không? Hiểu về các biến chứng của bệnh. Điều trị viêm cầu thận kịp thời, đúng cách là cần thiết, giúp hạn chế tối đa nguy cơ biến chứng, ảnh hưởng đến sức khỏe thận.